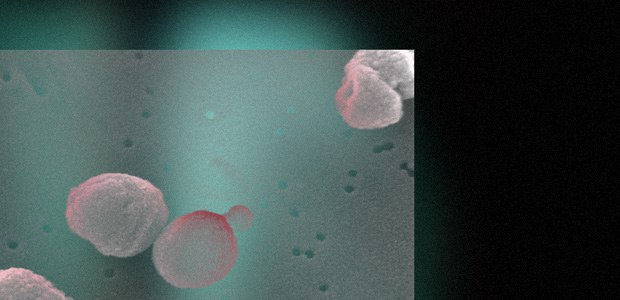

Size: a a a
2020 March 17






2020 March 18






Отмена клеточной смерти нейронов помогла обонятельной системе дрозофил эволюционировать
https://clck.ru/MYQnG
https://clck.ru/MYQnG







Первая ступень Falcon 9 не смогла вернуться после вывода спутников на орбиту. Это был ее пятый запуск
https://clck.ru/MYgX3
https://clck.ru/MYgX3